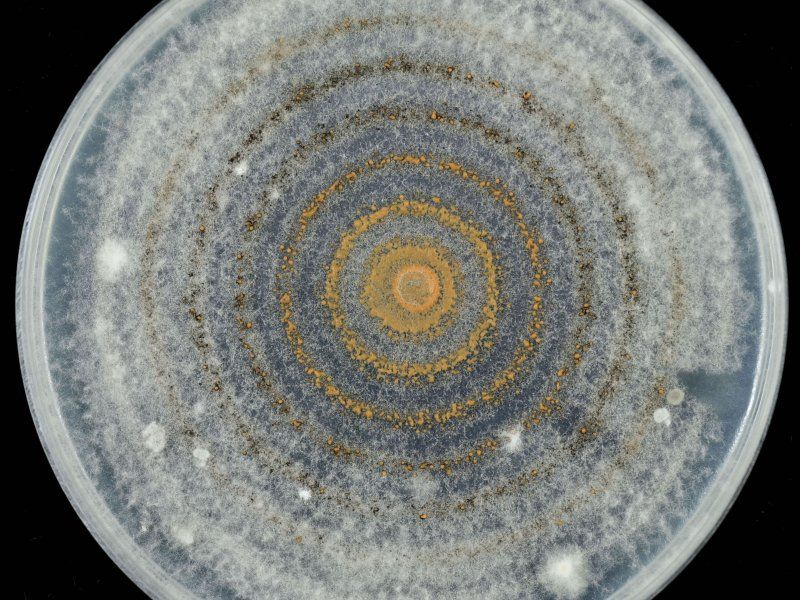
Blueberry disorders and diseases

Antracnose rot
Blueberries infected by fungi causing anthracnose can be recognised by sunken-brown lesions or by the growth of orange mycelium. The optimum temperature for anthracnose development is 20-27 °C. If the supply chain is maintained at a low temperature, the chances for anthracnose development are very low as the fungi causing it are relatively inactive below 15 °C. Infected berries should be taken out of the food chain.